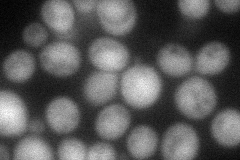
YOL128C

View description
Protein kinase related to mammalian glycogen synthase kinases of the GSK-3 family; GSK-3 homologs (Mck1p, Rim11p, Mrk1p, Ygk3p) are involved in control of Msn2p-dependent transcription of stress responsive genes and in protein degradation
Localization:
Intensity:
Fold change:
Significance:
-
C’ GFP library in SD

cytosol23.28 -
N' NOP1pr-GFP in SD

cytosol48.7492 -
N' TEF2pr-mCherry in SD
nucleus52.3554 -
N' NATIVEpr-GFP in SD

below threshold18.5041 -
N' TEF2pr-VC and Cyto-VN in SD

#N/A0 -
C’ GFP library in SD+DTT

cytosol17.930.77No -
C’ GFP library in SD+H2O2

cytosol19.740.84No -
C’ GFP library in Starvation Media

cytosol22.260.95No -
C’ GFP library on the background of Pup2-DaMP

N/A -
C’ GFP library on the background of CCT mutant

N/A0N/AYes
